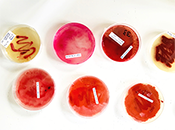

Index¶
Here are the weekly assignments:
 State of art |
 Digita Bodies |
 Circular Fashion |
Biochromes |
 e-textiles |
 Biofabricating Materials |
 Computational Couture |
 Open Source Hardware |
 Wearables |
 Textile as Scafold |
 Soft Robotics |
 Skin Electronics |
In week 11 I proposed my final project.